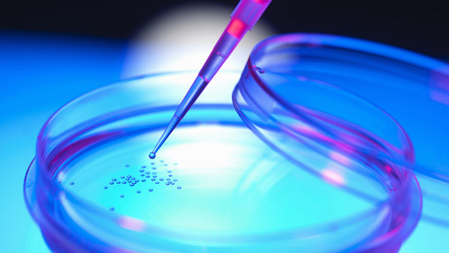
https://www.z3xmi.it/get image/caso stamina web https://www.z3xmi.it/get image/caso stamina web

Fecondazione eterologa equiparata all'omologa. La Consulta Bioetica al Ministro Lorenzin.
Lettera aperta indirizzata al Ministro Lorenzin. La Consulta Bioetca sottolinea l'equiparazione della fecondazione eterologa all'omologa stabilità dalla Corte Costituzionale con la sentenza n. 162/2014. Non sussiste pertanto nessun vuoto normativo circa la filiazione e la genitorietà.
La Sentenza deve solo essere applicata.
Autostima. Riflessioni per accrescerla
La bassa autostima è un problema molto diffuso che ha risvolti a volte anche gravi. Sentirsi meno degli altri e l’insicurezza sono solo alcune delle conseguenze. La persona con bassa autostima ha difficoltà a prendere delle decisioni, a lanciarsi in progetti nuovi a prendere l’iniziativa penalizzando così la sua vita. Ci possono essere inoltre problemi nella relazione di coppia scivolando in certi casi in situazioni di dipendenza affettiva.
Da Di Bella al caso Stamina
Un confronto fra i due casi che, negli ultimi anni, hanno in qualche misura, “sconvolto” il rapporto fra sanità-giustizia-mass media-politica, può forse essere utile, per capire quanta poca strada si sia fatta nel nostro paese e quanta confusione persista fra alcune fondamentali questioni: il diritto alla salute, la libertà di cura e i doveri dei medici.
Si alla fecondazione eterologa. Cade l'articolo della legge 40
È deciso. La Consulta ha dichiarato incostituzionale l'articolo della legge 40 che vieta la fecondazione eterologa in Italia.
La Casa Rosa migra in Zona 3
La Casa Rosa, associazione al femminile da anni conosciuta per il suo lavoro sulle problematiche femminili legate in particolare modo alla genitorialità, si è trasferita nel neo nato Centro Specialistico Camedi in zona 3 a Milano.
Arteterapia, immagini che curano
«…spesso accade che le mani sappiano svelare un segreto attorno a cui l'intelletto si affanna inutilmente» (Carl Gustav Jung).
L’arteterapia consiste nell’utilizzo dei mezzi di espressione artistica all’interno dei percorsi di terapia e di psicoterapia. Consolidata all'estero, in Italia viene ancora poco utilizzata e solo recentemente è stata riconosciuta la formazione in arteterapia di Art-Therapy.
Il sesso non fa male al cuore femminile
Le donne riprendono spesso una normale attività sessuale dopo l’infarto, ma sarebbe più facile superare la paura se i loro medici le informassero di più, almeno secondo uno studio pubblicato sul Journal of the American Heart Association.
Linee guida a sostegno del parto naturale
Uno studio olandese pubblicato sul BMJ ha fatto il punto sugli esiti del parto in casa, rilevando una sostanziale sicurezza per le donne che non presentano un profilo di rischio soprattutto se non si tratta del primo parto.